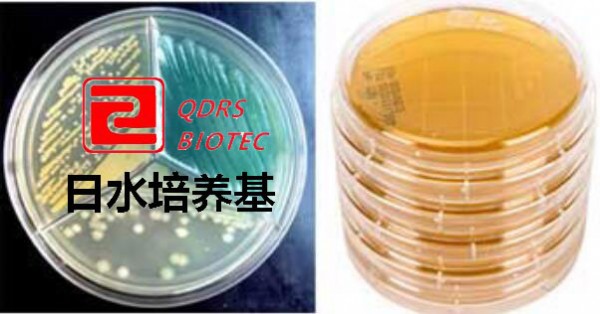

表面接触皿TSA卵磷脂吐温80日水生物
产品名称表面接触皿(NA)
生产标准GB、中国药典
包装规格内容物15~20ml/个,55mm×10个/包,三层真空包装
接触碟用途用于设备、车间、人员、包装材料等微生物的测定及细菌的纯化培养
英文名称Nutrition Agar
表面接触皿使用方法
1、从培养基存放处取出平皿,并恢复至工作室温.
2、将包装整体送入试验地点.
3、打开接触皿上盖,使培养基充分接触待测表面,必要时使用手指轻轻按压接触皿底部zhong心约10秒,轻轻抬起,将上盖从接触皿一侧小心盖上.
4、用消毒剂或杀孢子剂擦拭测试区域,以消除培养基的残留.
5、将接触皿从洁净室取出,按规定的温度和时间倒置培养.
6、观察、计数.
青岛日水生物培养基相关产品:
32724P-1胰酪大豆胨琼脂(TSA)90mm×10个/包
32724R-1胰酪大豆胨琼脂培养基(TSA)55mm×10个/包
32724S-1胰酪大豆胨琼脂(TSA)75mm×10个/包
32724P-5胰酪大豆胨琼脂培yang基(TSA+tou孢菌素酶)90mm×10个/包
32724P-7胰酪大豆胨琼脂(TSA+luan磷脂+吐温80)90mm×10个/包
30107营养琼脂(NA)90mm×10个/包
30130表面接触皿(NA)55mm×10个/包
30131表面接触皿(TSA)55mm×10个/包
32724P-101胰酪大豆胨琼脂pei养基(TSA)(进口)90mm×10个/包
32724R-101胰酪大豆胨琼脂(TSA)(进口)55毫米×10个/包
30140大豆酪蛋白琼脂培养基(TSA)90毫米×10个/包
30141大豆酪蛋白琼脂(青mei素酶)100万90毫米×10个/包
30149大豆酪蛋白琼脂培养ji(卵lin脂+吐温80)90毫米×10个/包
30149-1大豆酪蛋白琼脂(吐温80)90毫米×10个/包
31116改良马丁琼脂培养基90毫米×10个/包
31117大豆酪蛋白琼脂(TSA)150毫米×2个/包
30168大豆酪蛋白琼脂培yang基(头孢菌su酶)400万90毫米×10个/包
30169大豆酪蛋白琼脂(TSA)75毫米×10个/包
30169-1大豆酪蛋白琼脂PEI养基(TSA)75毫米×8个/包
31503胰蛋白胨大豆琼脂(头孢jun素mei)80万75毫米×10个/包
本页产品地址:http://www.geilan.com/sell/show-9121535.html